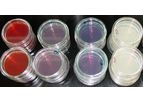
Measurements

- Home
- Companies
Refine by
Industries served
- Environmental
- University / Academia / Research
- Water and Wastewater
- Energy
- Agriculture
- Waste and Recycling
- Monitoring and Testing
- Air and Climate
- Health and Safety
- Chemical & Pharmaceuticals
- Soil and Groundwater
- Government
- Mining
- Medical / Health Care
- Oil, Gas & Refineries
- Manufacturing, Other
- Publishing / Media / Marketing
- Automobile & Ground Transport
- Aerospace & Air Transport
- Forestry & Wood
- Metal
- Food and Beverage
- Defense
- Electronics and Computers
- Packaging
- Leather & Tanning
- Paint
- Plastics & Resins
- Pulp & Paper
Environmental Industry Research Institute
189 companies found
Research institutebased inBerlin, GERMANY
The IÖW is a leading scientific institute in the field of practice-oriented sustainability research. It devises strategies and approaches for viable, long-term economic activity – for an economy which enables a good life and preserves natural ...

Research institutebased inMoscow, RUSSIA
“Lytech” Co. Ltd. was established in 1992 as a Research and Production Company on the basis of Scientific Research Institute of Physical-Chemical Medicine. “Lytech” was one of the first companies in Russia which introduced a polymerase chain ...
DNA-Express, NA Sorbent Base, NA Sorbent Sputum. Extraction of NA from sputum, NA Sorbent Tissue. Extraction of NA from tissues, NA Sorbent Feces. Extraction of NA from feces, NA Sorbent Blood. Extraction of NA from whole blood, NA Sorbent Serum. ...

Research institutebased inRoorkee, INDIA
CESER Publications was established in 1999 as a scholarly publisher. From that beginning, CESER Publications has been dedicated to the advancement and dissemination of knowledge to scholars, students, the scientific and academic societies. CESER ...
Research institutebased inFreiburg, GERMANY
The Oeko-Institut is one of Europe’s leading independent research and consultancy organisations working for a sustainable future. Founded in 1977, it develops principles and strategies for realising the vision of sustainable development at global, ...
Accounting & Personnel Department is a part of the Institute’s central services. It helps the Institute’s research divisions concentrate on their scientific ...

Research institutebased inMadrid, SPAIN
The Spanish National Research Council (CSIC) is the largest public research institution in Spain and one of the most renowned institutions in the European Research Area (ERA). It is affiliated to the Ministry of Science and Innovation through the ...
The are many alternatives for joining and working in the CSIC: to do it as a researcher, it is required to be in possession of the title of doctor; as a researcher in training, through a predoctoral contract; as technician, supporting research ...
Research institutebased inkiel, GERMANY
Internatinal dairy research center concerns about dairy industry development worldwide, dairy economics, environmental issues, dairy sectors ...

Research institutebased inStockholm, SWEDEN
Stockholm International Water Institute (SIWI) provides and promotes water wise solutions for sustainable development in five thematic areas: water governance, transboundary water management, climate change and water, the water-energy-food nexus, ...
Water governance determines how we as individuals and as a society manage, use and allocate resources and distribute ...
Research institutebased inDuebendorf, SWITZERLAND
Eawag is a world-leading aquatic research institute. Its research, which is driven by the needs of society, provides the basis for innovative approaches and technologies in the water sector. Through close collaboration with experts from industry, ...

Research institutebased inDresden, GERMANY
The Fraunhofer Institute for Ceramic Technologies and Systems IKTS, situated in Dresden and Hermsdorf, covers the complete field of advanced ceramics, from basic research to applications. Our services include the development and application of ...
At Fraunhofer IKTS, an interdisciplinary team of chemists, physicists, and materials scientists work in six research fields with the support of experienced technicians and research engineers. Focus is on ceramics manufacturers and users as project ...

Research institutebased inStockholm, SWEDEN
IVL Swedish Environmental Research Institute is an independent, non-profit research institute, owned by a foundation jointly established by the Swedish Government and Swedish industry. IVL Swedish Environmental Research Institute was established in ...
We offer a variety of measurements for both emissions as well as the state of different environmental settings and matrices. Our measurement expertise spans virtually all areas of society, from industrial processes and mobile emission sources to ...
Research institutebased inSaint-Hyacinthe, QUEBEC (CANADA)
IRDA carries out research activities which allow the advancement of knowledge and the development of technology essential to the protection of the environment and the development of agri-food systems. ...
Asserva-300 Decanter centrifuge; hydraulic treatment capacity of 5 m3/hour (1.3 to 2.5 m3/hour for liquid swine manure); 60 kW auxiliary power unit; transfer pumps, conveyor, tanks and flexible pipes; laboratory equipped for field ...
Research institutebased inPlymouth, UNITED KINGDOM
Our science is mission driven and delivers a valuable, integrated approach to solving problems and providing solutions concerning the complexity of marine ecosystems and the unique bioresources they contain. PML’s research mission blends ...
Research institutebased inNewcastle, CALIFORNIA (USA)
Mother Lode Reclamation a non-profit organization that has been Mandated by the Government of Ghana to reclaim and restore the thousands of acres of mined land left by illegal Galamsey miners. The President has stated that it is the responsibility ...

Research institutebased inDresden, GERMANY
The Leibniz-Institut für Polymerforschung Dresden e. V. (Leibniz Institute of Polymer Research Dresden) is one of the largest polymer research institutions in Germany. As a member institute of the Leibniz-Gemeinschaft (Leibniz Association) it is ...
Control, characterization, and modelling of structure formation processes and of materials properties in reactive processing of multifunctional polymer and elastomer materials.Interface design in multicomponent and multifunctional composite ...

Research institutebased inHalle (Saale), GERMANY
The Fraunhofer Center for Silicon Photovoltaics (CSP) conducts applied research in the area of crystallization, solar modules and solar wafers. With top competencies, Fraunhofer CSP explores the field of ingot manufacturing and material development. ...
The optical properties of solar cells and solar modules, in particular the materials used for the body of the solar module, are of significant importance for their efficiency. The optical interaction of the cover glass, the anti-reflective coating, ...

Research institutebased inOntario, CALIFORNIA (USA)
IAPMO R&T is North America’s premier plumbing and mechanical product certification agency. It is accredited by American National Standards Institute (ANSI) and Standards Council of Canada (SCC). IAPMO R&T has reduced completion time of third-party ...

Research institutebased inBrighton, UNITED KINGDOM
The Environmental Systems and Processes Research Group (ESPRG) brings together researchers interested in animals and plants and their interactions with their environment. The fusion of the study of ecology, animal behaviour, plant science and ...
Residential, Sport and Trading Services is responsible for the development and delivery of housing, sport, catering, retail, conferences and childcare at Sussex. RSTS supports and enhances the student and staff experience, in line with agreed ...

Research institutebased inLondon, UNITED KINGDOM
UK Energy Research Centre carries out world-class research into sustainable future energy systems. It is the hub of UK energy research and the gateway between the UK and the international energy research communities. Our interdisciplinary, whole ...
Research institutebased inMol, BELGIUM
VITO, the Flemish institute for technological research, is an independent research centre, a crossroads of knowledge where the latest technologies and practical applications meet. VITO conducts customer oriented contract research and develops ...
VITO is a leading independent European research and consulting centre active in the area of materials, environment, health, nutrition, chemicals, etc. Since its foundation analytical researchers have built up a broad experience using both routine ...

Research institutebased inLaramie, WYOMING (USA)
Western Research Institute (WRI) is a technology development center serving private clients, industry, and government with expertise in energy, environment, and highway materials. We work with our partner-clients to bring together the knowledge and ...
The Automated Flocculation Titrimeter (AFT) automates the collection of Heithaus values, allowing users to easily and reliably predict which heavy oils and petroleum residua (including asphalts) can be mixed without causing phase separation. ...